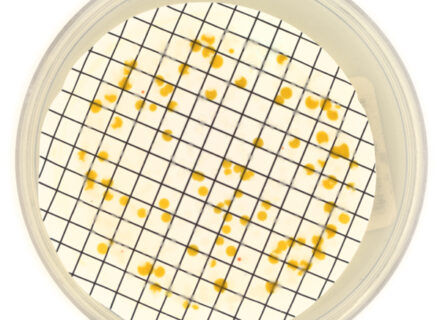

PIXL Max
Faster, Smarter Colony Picking

| Integrability |
|
ColonyCam VOGUE
High-throughput Phenotyping

| High-resolution imaging |
|
| Fluorescence detection |
|
| Integrability |
|
| Lid-on imaging |
|
PhenoBooth+
Multi-mode Colony Counter

| High-resolution imaging |
|
| Fluorescence detection |
|
| Integrability |
|
| Lid-on imaging |
|